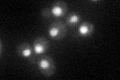
YOR048C
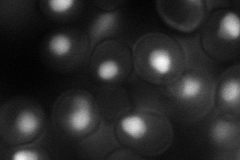
YOR048C
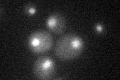
YOR048C

View description
Nuclear 5' to 3' single-stranded RNA exonuclease, involved in RNA metabolism, including rRNA and snRNA processing as well as poly (A+) dependent and independent mRNA transcription termination
Localization:
Intensity:
Fold change:
Significance:
-
C’ GFP library in SD
nucleus40.61 -
N' NOP1pr-GFP in SD
nucleus79.8646 -
N' TEF2pr-mCherry in SD

cell periphery,vacuoleN/A -
N' NATIVEpr-GFP in SD

missing0 -
N' TEF2pr-VC and Cyto-VN in SD

#N/A0 -
C’ GFP library in SD+DTT

nucleus33.090.81No -
C’ GFP library in SD+H2O2

nucleus44.651.09No -
C’ GFP library in Starvation Media
nucleus26.250.64Yes -
C’ GFP library on the background of Pup2-DaMP

nucleus -
C’ GFP library on the background of CCT mutant

nucleus44.33211.09145No
